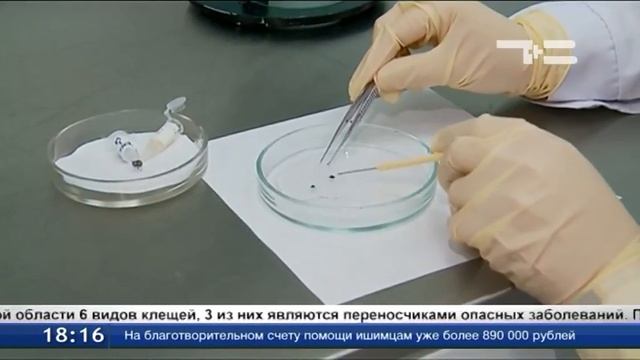
От клещей пострадало более 400 детей смотреть онлайн

Автор / Канал: Эзотерическая магия чувственной игры Страница 5

Spider-Punk, Miles Morales, Gwen Stacy, The Spot, Bag-Man FACE | Coloring Page

S01E51 ВАЗ 21130 Подготовка к сварке.

ЕДУ ДОМОЙ /ЗАТОПИЛИ СОСЕДЕЙ *влог

Max Payne - Кошмары из снов - #5

Свадебный букет -- атрибут счастья

Ярослав Климанов. Сон о проводах разведчика. #ТВОРЧЕСТВО #КЛИМАНОВ #СМЫСЛ

Многие не любят других из-за того,что много говорят.А кошек,или котят,что постоянно мяукают.

Georgs Pelecis - Nevertheless concerto for violin, piano and strings
От клещей пострадало более 400 детей

Голуби сидят на купола церкви

Ловушки в Minecraft. Ловушки для животных.

Dishonored : Hardcore Kill Moment : Прохождение игры

MIRSADIKOVA BILAN KIDS 2

"Михаил Радуга", жуткий мазохизм; - фазовая шизофрения продолжается!

Обзор смарт часов NO.1 G2

Оставили БЕЗ ЗУБОВ в Турции! ?

Март. Прогулка после сна.

Комплект штор «Летний день»

Прохождение Соник мания плюс за теелза

Платон. Протагор #13. 330b-334c.

Вы будете мечтать об этом блюде снова и снова | Острый Тхабо с рисом

Странный сон!\Ко мне пришли БЕС и Моя СОВЕСТЬ\Машка ушла на Английский а я прогуляла\ Для детей.

256205 PIANO 4x2 Дуб бунратти; Стеллаж.

Курочка по зернышку клюёт тук тук тук!
За каждым успешным каналом стоит личность, идея и сотни часов кропотливого труда. Если вы здесь, значит, автор «Эзотерическая магия чувственной игры» уже сумел зацепить ваше внимание своим уникальным стилем или подачей. А мы на RUVIDEO позаботились о том, чтобы вы могли изучить весь архив его работ в максимально комфортных условиях — без лишней суеты и преград.
Почему за работами канала «Эзотерическая магия чувственной игры» так интересно наблюдать? Всё просто: это честный контент, который находит отклик в сердцах зрителей. На нашем ресурсе вы можете смотреть онлайн все видео любимого автора бесплатно и в хорошем качестве. Нам важно, чтобы вы видели каждую деталь и слышали каждый нюанс, поэтому мы используем только стабильные плееры из открытых источников Rutube.
Следите за новинками канала, пересматривайте старые шедевры и открывайте для себя новые грани творчества «Эзотерическая магия чувственной игры». Мы постоянно обновляем ленту, чтобы у вас под рукой всегда были самые свежие выпуски. Никаких сложных регистраций — только вы и творчество, которое вдохновляет. Приятного вам путешествия по миру авторского контента на RUVIDEO!
Видео взято из открытых источников Rutube. Если вы правообладатель, обратитесь к первоисточнику.